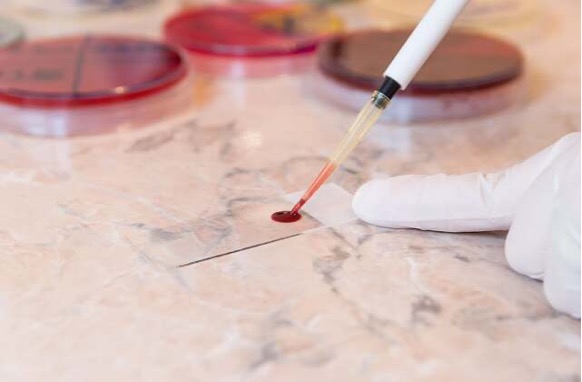

2025-06-12
来源: drugdu
204
作者:丹尼斯·汤普森(健康日记者) 2025年6月10日(健康日新闻)——一项新的小型试点研究称,血液检测能够比癌症原本的诊断时间提前三年发现其存在的迹象。
这种检测被称为多癌早期检测(mced)检测,其目的是寻找肿瘤细胞释放到血液中的遗传物质。
根据近期发表在《癌症发现》杂志上的研究结果,该测试发现,在一些患者被确诊患有癌症之前,其血液中就已经存在癌细胞 dna 了,且这种情况持续了长达三年半之久。
资深研究者尼古拉斯·帕帕多普洛斯(约翰斯·霍普金斯大学路德维希癌症研究中心的肿瘤学教授)表示:“在癌症出现临床症状之前提前数年进行检测,能够帮助医疗团队制定出更有利的治疗方案。”
“当然,对于此类癌症的阳性检测结果,我们还需要确定相应的临床随访措施,”他在一份新闻稿中补充道。
在此次研究中,研究人员对为一项由联邦政府资助、旨在研究心脏病的大型项目所采集的血液样本进行了检测。
该团队采用 mced 测试对 26 名在提供血液样本后六个月内被确诊患有癌症的研究对象与另外 26 名未患癌症的类似对象进行了对比分析。
在 52 份血液样本中,有 8 份在 mced 检测中呈阳性反应。结果显示,这 8 位患者在提供样本后的四个月内被确诊患有癌症。
其中有三人患有结肠癌,另外一人分别患有胰腺癌、直肠癌、肺癌、乳腺癌或肝癌。这八名患者中,有五人最终因癌症而去世。
再往前追溯的话,研究人员从这 8 名患者中选取了 6 名患者的血液样本,这些样本是在他们被确诊患有癌症的三年至三年半之前采集的。
该团队在其中四份早期样本中发现了肿瘤脱落的 dna,这表明这些患者的癌症可能早在数年之前就已经被发现。
“这项研究表明,基于微流控芯片的检测技术在早期发现癌症方面具有巨大潜力,并确定了这些技术取得成功所需的灵敏度基准值。”资深研究员伯特·沃格尔斯坦博士在一份新闻稿中说道。他是约翰斯·霍普金斯大学肿瘤学教授以及路德维希研究中心的联合主任。
还需要进行更大规模的研究来证实这些发现,但研究者表示,这些结果表明这种血液检测手段很有可能能在癌症更早期、更易治愈的阶段将其检测出来。
研究人员在论文中写道:“我们这项研究的重点并非是展示一种新的 mced 检测方法的性能,而是要展示任何 mced 检测方法都能如何尽早检测出(血液中的癌症 dna)。”
研究人员还指出,要想在癌症确诊前三年或更长时间就进行检测,所使用的血液检测方法必须比用于诊断前六个月的检测方法灵敏 50 倍以上。
该团队写道:“为实现这一基准而开发相关技术是一个极具意义的未来目标。”
凯发k8天生赢家一触即发的版权所有 © 2025 健康日(healthday)公司。凯发k8天生赢家一触即发的版权所有。
责编: editor